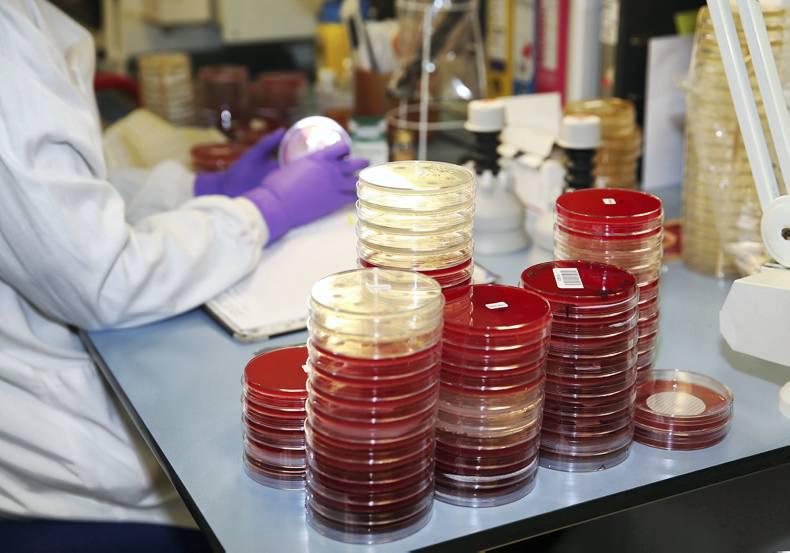

Horse Racing Ireland (HRI) today published a report by the Irish Thoroughbred Industry Anti-Doping Task Force, setting out recommendations to ensure that the drug testing regime for Ireland’s racing and breeding sectors operates to the highest international standards.
HRI has also approved expenditure of €1.845m to purchase new laboratory equipment and ensure appropriate facilities to continue to meet the challenges being faced in this area. The equipment will be installed in phases from 2016, with the first order having already been placed.


This is a subscriber-only article
It looks like you're browsing in private mode

SHARING OPTIONS: